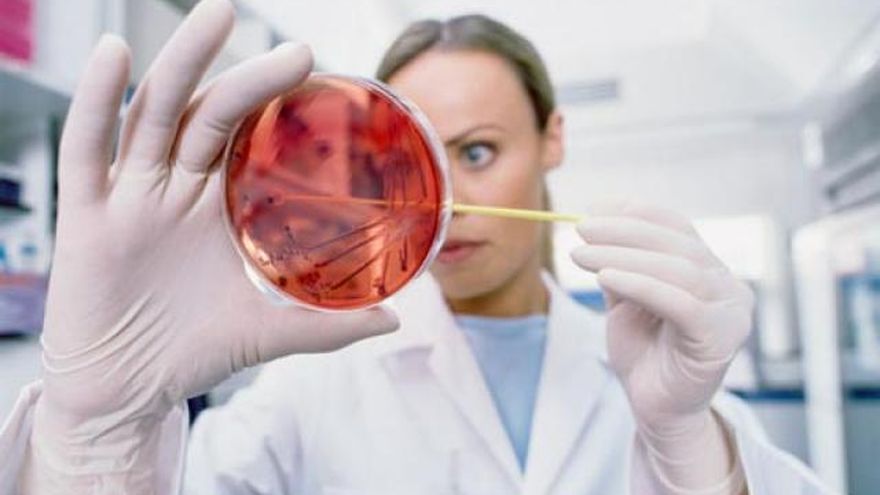

TVN Noticias Edición Mediodía
En vivo
Científicos españoles han descrito por primera vez la presencia de opioides en las células implicadas en la formación de espermatozoides, informó hoy la Universidad del País Vasco (UPV-EHU).
Este trabajo, publicado en la revista científica Plos One y dirigido por la investigadora de la UPV (norte de España) Nerea Subirán, revela que los receptores opioides forman parte de los diferentes sistemas de comunicación celular y regulan procesos fisiológicos que requieren un alto grado de coordinación entre los distintos tipos de células y tejidos.
"Aunque se trata de investigación de ciencia básica con modelos animales, estos estudios van arrojando luz sobre los mecanismos moleculares que controlan la fertilidad masculina", explicó Subirán.
El estudio describe cómo los receptores opioides participan en la producción de los espermatozoides en los mamíferos y desvela que su activación regula la formación de la maquinaria que se encarga de la correcta segregación de la información genética durante la espermatogénesis.
Los opioides son receptores celulares para neurotransmisores del sistema nervioso de los grandes mamíferos y su existencia se descubrió en los años setenta ante la multiplicidad de respuestas farmacológicas que produce la administración externa de opiáceos.
El estudio contribuye a entender mejor las causas de muchos casos de infertilidad y permite "abrir nuevos horizontes en el desarrollo de dianas y estrategias terapéuticas para combatirla", según esta doctora en Fisiología y profesora en el Departamento de Fisiología de la UPV/EHU.
